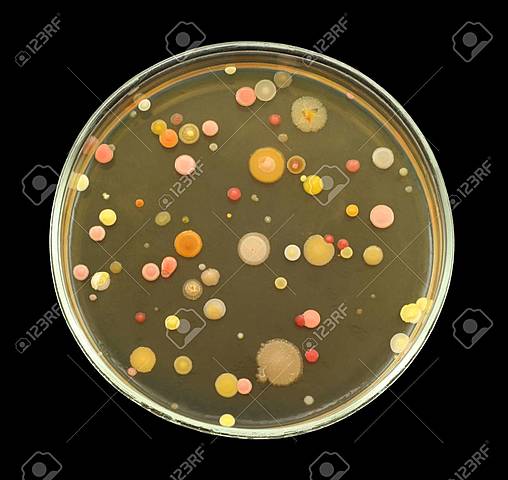
Robert Koch describe colonias bacterianas creciendo en rodajas de papa, medio gelatinoso y medio agarizado.

-
-
Se establecen procesos de fermentación, especialmente en China. La transformación de la leche por bacterias
-
-
Egipto y Persia dejan de lado estos procesos por influencia del Islam. Los cereales fermentados son base de la dieta africana
-
la contraparte masculina aporta el polen y la femenina los ovocitos. Pasaran mas de 200 años hasta corroborarse por microscopía la existencia de los gametos
-
Pasarán 200 años hasta que las técnicas microscópicas permitan a los científicosdescubrir que todos los orgsnismos estan compuestos por células.
-
La vacunación (infección intencional a los humanos con el virus de la viruela bovina para inducir resistencia a viruela) con la inoculación (infección a los humanos con una cepa suave de viruela para inducir resistencia a cepas más severas de la enfermedad). Sus ideas surgen de observar que las personas expuestas al virus de la viruela bovina, no eran vulnerables al virus de la viruela humana.
-
-
Mecanismo de evolución de las especies. Su libro “El origen de las Especies” se publica en Londres.
-
Mendel propone que existen unidades o factores de información responsables de los caracteres observables, y que tales “factores” (luego conocidos como genes) son transmitidos de una generación a la siguiente. El trabajo de Mendel permaneció ignorado hasta 1900, cuando los científicos De Vries, Von Tschermak y Correns corroboran el mecanismo propuesto por Mendel.
-
El agar nutritivo se convierte en una herramienta común para
obtener cultivos puros y para identificar mutantes. Esto es considerado como uno de los descubrimientos más importantes que originó la microbiología. En el mismo año, Pasteur utiliza la atenuación para desarrollar vacunas contra patógenos bacterianos responsables del cólera aviario y del ántrax y resulta clave en la historia de la inmunología ya que se abre el campo de la medicina preventiva. -
-
Ese mismo año se demuestra por primera vez que algunos químicos claves para la industria (glicerol, acetona y butanol) pueden ser generados utilizando bacterias.
-
Este hallazgo conduce al desarrollo de la técnica de “cristalografía de rayos X”, que posibilitará explorar las estructuras tridimensionales de ácidos nucleicos y proteínas, jugando un rol crítico para el descubrimiento de la estructura de la molécula de ADN años más tarde.
-
-
Luego de 16 años, Oswald Avery identificará la naturaleza de tal principio transformante: ADN. En otras áreas, Lewis Stadler demuestra que la radiación U.V. también puede inducir mutaciones, y Alexander Fleming observa que todas las bacterias creciendo en
un radio alrededor de la especie de hongo filamentoso (moho) Penicillium notatum mueren, comenzando así la era de la penicilina. Pasarán más de 15 años hasta que la penicilina esté disponible para su uso médico por la comunidad. -
Oswald Theodore Avery, Colin MacLeod y Maclyn McCarty determinaron que el ADN es el material hereditario involucrado en la
transformación de las bacterias de fenotipo rugoso a liso. Al principio, esta hipótesis no tendría muchos adeptos, porque la molécula de ADN parecía demasiado simple para contener
toda la información genética de un organismo, a diferencia de las proteínas. -
Estas relaciones se conocerían luego como la “regla de Chargaff”, sirviendo como principio clave en los análisis de varios modelos de estructura del ADN por Watson y Crick. En el área agropecuaria, se logra la inseminación artificial del ganado, utilizando semen congelado.
-
Sugiere que la información genética fluye en una sola dirección, desde el ADN, pasando por ARN mensajero, finalizando en la síntesis de proteínas (concepto central que luego sería modificado con el descubrimiento de la replicación de los retrovirus como el HIV). Matthew Meselson y Franklin Stahl demuestran el mecanismo de replicación del ADN.
-
Examinándola, descubre que el triplete de bases Uracilo (UUU)
codifica para el aminoácido fenilalanina. Este fue el primer paso en el descifrado del código
genético. -
Las semillas serían liberadas por el Programa Agrícola Mexicano a otros países.
-
utiliza también una enzima ligasa para pegar dos fragmentos de ADN, formando una molécula híbrida circular, generando así la primer molécula de ADN recombinante. En una carta pública, Berg y colegas proponen al Instituto Nacional de Salud de EE.UU. (NIH) generar un conjunto de guías para regular los experimentos con ADN recombinante, hasta que se pudieran resolver cuestiones relacionadas con la bioética y la bioseguridad de los mismos..
-
Stanley Cohen, Annie Chang y Herbert Boyer ensamblan fragmentos de ADN viral y bacteriano cortando con la misma enzima de restricción, creando un plásmido recombinante. Luego lo introducen en la bacteria Escherichia coli, produciendo así el primer organismo recombinante, transgénico o genéticamente modificado.
-
Los científicos piden al gobierno que adopte normas para
regular la experimentación con ADN recombinante, e insisten en el desarrollo de cepas de bacterias “seguras” que no salgan del ámbito del laboratorio. Por su parte, Georges Kohler y el argentino César Milstein fusionan células para producir anticuerpos monoclonales. -
Ese año, David Botstein y colaboradores, descubren que la aplicación de enzimas de restricción al ADN de diferentes individuos genera una serie única e individual de fragmentos, pudiendo ser este patrón usado como una “huella digital” genética. A este tipo de “marcador molecular” se lo conoce como RFLP (polimorfismo en el largo de los fragmentos de restricción), y resulta muy útil para estudios genéticos en todo tipo de organismos.
-
Científicos producen los primeros animales transgénicos: son ratones. En el área vegetal, se obtienen los primeros callos vegetales transformados genéticamente.
-
En EE.UU. la Agencia de Protección Ambiental (EPA, en inglés) aprueba la liberación del primer cultivo modificado por ingeniería
genética: tabaco. El NIH, por su parte, aprueba guías para realizar ensayos clínicos de terapia génica en humanos. Las empresas Caltech y Applied Biosystems, Inc, desarrollan el secuenciador automático de ADN por fluorescencia. La FDA otorga una licencia a Chiron Corp. para la primer vacuna recombinante (para prevenir la hepatitis B). -
Dirigido por James Watson, con el objetivo de mapear y secuenciar el genoma humano completo para el año 2005, y contará para ello con la suma de 3 mil millones de dólares.
-
En la formulación e implementación de la regulación para la introducción y liberación al ambiente de materiales animales y vegetales obtenidos mediante Ingeniería Genética: la Comisión Nacional Asesora de Biotecnología Agropecuaria (CONABIA).
-
probando la posibilidad de los xenotransplantes
(transplante de un órgano o de un tejido desde un animal a otro de distinta especie). En diciembre del mismo año, se realiza en el Hospital General de San Francisco, el primer transplante de médula ósea (pretratada) de un babuino a un paciente humano enfermo de Sida, con la intención de reforzar su sistema inmunológico con células del mismo tipo pero resistentes a la infección por el VIH como son las células de estos animales. -
A partir de una célula de la ubre de una oveja adulta. Se
completa la secuenciación del genoma de Borrelia burgdorferi, patógeno causal de la enfermedad de Lyme, junto con los genomas de Escherichia coli y Helicobacter pylori(bacteria causal de la úlcera gástrica). También se aprueba el Rituxan, el primer medicamento para una terapia anticancerígena basada en anticuerpos (para pacientes enfermos de linfoma no Hodkin). -
-
-
En Argentina, se aprueban para su comercialización un maíz transgénico con tolerancia a glufosinato de amonio y resistencia
a lepidópteros, y otro maíz transgénico tolerante a glifosato. Se cumplen 10 años de cultivos GM en Argentina. Los beneficios económicos a nivel nacional acumulados desde el comienzo de su adopción, en 1996; ascienden a 20 mil millones de dólares. -
Además se completa la secuencia del genoma de la soja, del
durazno, del manzano, del ricino y de una gramínea del grupo del trigo y la cebada. Se comercializan las primeras enzimas para la producción de etanol celulósico. Investigadores argentinos logran clonar espermatozoides. Científicos de Estados Unidos crean la primera célula controlada por un genoma sintético. En Argentina, investigadores clonan por primera vez un caballo. -
Por otro lado, un consorcio internacional formado por 150 investigadores de 12 países secuencian los genomas del cerdo y el jabalí. La Administración de Alimentos y Fármacos de EE.UU. aprueba el primer medicamento producido por zanahorias genéticamente modificadas para uso en pacientes con enfermedad de Gaucher. De la mano del INTA, la Argentina y otros 12 países secuencian el genoma del tomate.
-
Además un equipo de investigadores de diferentes países secuencia y ensambla el genoma del kiwi. El Ministerio de Agricultura, Ganadería y Pesca anuncia la renovación y modernización del marco regulatorio argentino para OGM, que acumula 5 aprobaciones comerciales en soja, 20 en maíz y 3 en algodón, además de más de 1.000 autorizaciones para ensayos a campo.
Plan projects on a visual timeline
Map milestones, phases, deadlines, and key events in one place so the sequence is easier to see and share. Timetoast is a timeline maker for work, school, research, and stories.